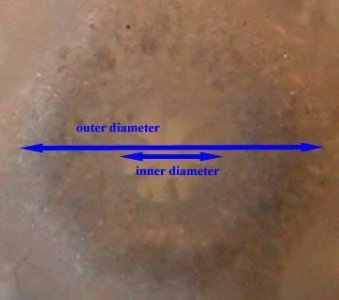

piercho
New member
Here is one I would like to identify. A whole colony was brought to a PSAS meeting and this image is of my fragment of that colony. It has encrusted on rock at the very back of the tank and cannot be readily removed to be photographed so the image here is poor. The fragment was mounted on it's side and instead of starting new growth from it's upper side coralites(what I expected), the existing axial coralites are bending up as they grow.
As I recall, there was a lot of anastomosing branches on the colony, especially in the lower, older, regions. The tips of the entire colony rose up to an even level like a tabletop, but this may be because they had reached the top of the water in the tank, I don't know. A form description that best applies - I would say - is corymbose. The anastomosing branches were generally in the lower, horizontal region and they terminate in short, upright branchlets. My fragment picured here is just an upright branchlet (mounted on it's side).
An image of a skeletal tip follows this post. I apologize for attaching photos rather than links, but the RC upload to gallery function is currently broken.
*edit* The upload image fuction also appears to be broken to attach images directly to a post. Hmmm.... I'll have to post back with links. Sorry.
As I recall, there was a lot of anastomosing branches on the colony, especially in the lower, older, regions. The tips of the entire colony rose up to an even level like a tabletop, but this may be because they had reached the top of the water in the tank, I don't know. A form description that best applies - I would say - is corymbose. The anastomosing branches were generally in the lower, horizontal region and they terminate in short, upright branchlets. My fragment picured here is just an upright branchlet (mounted on it's side).
An image of a skeletal tip follows this post. I apologize for attaching photos rather than links, but the RC upload to gallery function is currently broken.
*edit* The upload image fuction also appears to be broken to attach images directly to a post. Hmmm.... I'll have to post back with links. Sorry.